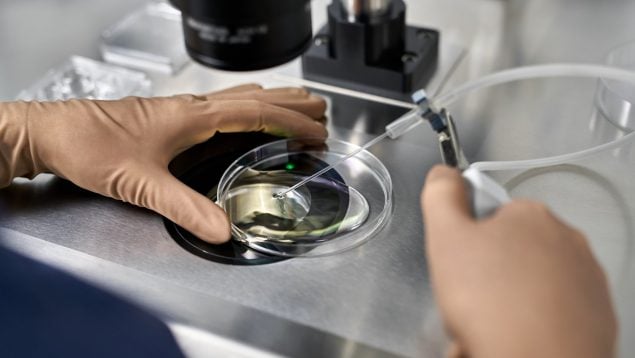

Un tratamiento contra el cáncer restablece la capacidad del sistema inmunitario para combatir tumores

Fact checked
Este artículo de OkSalud ha sido verificado para garantizar la mayor precisión y veracidad posible: se incluyen, en su mayoría, estudios médicos, enlaces a medios acreditados en la temática y se menciona a instituciones académicas de investigación. Todo el contenido de OkSalud está revisado pero, si consideras que es dudoso, inexacto u obsoleto, puedes contactarnos para poder realizar las posibles modificaciones pertinentes.
Un nuevo tratamiento contra el cáncer restablece la capacidad del sistema inmunitario para combatir tumores, como ha anunciado un equipo de investigación dirigido por científicos de la Universidad de Texas en Estados Unidos.
Desde hace algunos años, el sentido de la palabra cáncer ha sufrido una gran transformación en las últimas décadas. La esperanza de vida para los pacientes oncológicos se ha duplicado en los últimos 40 años, según el informe Las cifras del cáncer en España 2023 de la Sociedad Española de Oncología Médica (SEOM).
Gracias a la ciencia, ahora un nuevo tratamiento parece responder en modelos de ratón para tumores de melanoma, cáncer de vejiga, leucemia y colon. Este fármaco ralentiza el crecimiento de los tumores, prolonga la vida útil y potencia la eficacia de la inmunoterapia. La investigación, publicada en la revista Cancer Cell, podría cambiar las reglas del juego para muchos enfermos de cáncer.
Tramo de ADN
Muchos cánceres borran un tramo de ADN llamado 9p21, que es la deleción más común en todos los cánceres y se da en el 25%-50% de ciertos cánceres como el melanoma, el cáncer de vejiga, el mesotelioma y algunos cánceres cerebrales.
Los científicos saben desde hace tiempo que los cánceres con la deleción 9p21 tienen peores resultados para los pacientes y son más resistentes a las inmunoterapias, las estrategias de tratamiento diseñadas para potenciar la respuesta inmunitaria natural del paciente frente al cáncer.
La deleción ayuda a las células cancerosas a evitar ser detectadas y aniquiladas por el sistema inmunitario, en parte porque induce al cáncer a bombear un compuesto tóxico llamado MTA que impide el funcionamiento normal de las células inmunitarias y bloquea la eficacia de las inmunoterapias.
«En modelos animales, nuestro fármaco reduce el MTA a niveles normales y el sistema inmunitario vuelve a funcionar», explica Everett Stone, profesor asociado de investigación del Departamento de Biociencias Moleculares y profesor asociado de oncología de la Facultad de Medicina de Dell, que dirigió el trabajo.
«Vemos muchas más células T alrededor del tumor, y están en modo de ataque -añade-. Las células T son un tipo de célula inmunitaria importante, como un equipo SWAT que puede reconocer las células tumorales y bombearlas llenas de enzimas que mastican el tumor desde dentro hacia fuera».
Stone prevé que el fármaco se utilice en combinación con inmunoterapias para potenciar su eficacia.
La deleción 9p21 provoca la pérdida de algunos genes clave en las células cancerosas. Desaparecen un par de genes que producen reguladores del ciclo celular, proteínas que mantienen el crecimiento y la división de las células sanas a un ritmo lento y constante.
Sistema inmunitario
Cuando se pierden esos genes, las células pueden crecer sin control. Eso es lo que las convierte en cancerosas. También se ha eliminado un gen que produce una enzima que descompone la toxina MTA. Según Stone, esta pérdida permite a las células cancerosas adquirir un nuevo superpoder: la capacidad de desactivar el sistema inmunitario.
«El cáncer obtiene un dos por uno cuando pierde estos dos genes -afirma Stone-. Pierde los frenos que normalmente le impiden crecer de forma descontrolada. Y, al mismo tiempo, desarma a la policía del organismo. Así, se convierte en un tipo de cáncer mucho más agresivo y maligno».
Temas:
- Cáncer
- Tratamientos